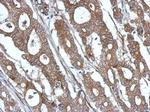
ISG15 Antibody in Immunohistochemistry (Paraffin) (IHC (P))

Search
Invitrogen
ISG15 Polyclonal Antibody
{{$productOrderCtrl.translations['antibody.pdp.commerceCard.promotion.promotions']}}
{{$productOrderCtrl.translations['antibody.pdp.commerceCard.promotion.viewpromo']}}
{{$productOrderCtrl.translations['antibody.pdp.commerceCard.promotion.promocode']}}: {{promo.promoCode}} {{promo.promoTitle}} {{promo.promoDescription}}. {{$productOrderCtrl.translations['antibody.pdp.commerceCard.promotion.learnmore']}}
图: 1 / 9
ISG15 Antibody (PA5-31865) in ICC/IF

Please note: We are reviewing Western blot images included in the antibody testing data in our catalog, including those provided by third parties. Unless expressly labeled or annotated as “raw-unedited”, Western blot images included in the antibody testing data in our catalog may have been edited, optimized or otherwise adjusted for presentation.
产品信息
PA5-31865
种属反应
已发表种属
宿主/亚型
分类
类型
抗原
偶联物
形式
浓度
规格
纯化类型
保存液
内含物
保存条件
运输条件
RRID
产品详细信息
Recommended positive controls: HeLa, rat spleen.
Predicted reactivity: Human (99%), Rhesus Monkey (90%).
Store product as a concentrated solution. Centrifuge briefly prior to opening the vial.
靶标信息
Ubiquitin-like protein ISG15 plays a key role in the innate immune response to viral infection either via its conjugation to a target protein (ISGylation) or via its action as a free or unconjugated protein. It is secreted from monocytes in response to type I interferons and causes natural killer (NK)-cell proliferation and an augmentation of non-MCH (major histocompatibility complex)-restricted cytotoxicity. Synthesis is stimulated by IFN-alpha or IFN-beta or IFN-omega, but not IFN-gamma. ISG15 expression is also induced by overexpression of interferon regulatory factors that participate in transcriptional regulation of IFN genes, and by influenza B virus. ISG15 is secreted by cell lines of monocyte, T-lymphocyte, B-lymphocyte, human fibroblasts, and epithelial origins. Enhancement of NK cell proliferation, augmentation of non-major histocompatibility complex-restricted cytotoxicity, and induction of IFN-gamma from T cells identify ISG15 as a member of the cytokine cascade and suggest that it may be responsible for amplifying and directing some of the immunomodulatory effects of IFN-alpha or IFN-beta. ISG15 has has also been shown to function intracellularly as a ubiquitin homolog. Mutations affecting the gene can result in Immunodeficiency 38, with basal ganglia calcification (IMD38).
仅用于科研。不用于诊断过程。未经明确授权不得转售。
生物信息学
蛋白别名: hUCRP; Interferon-induced 15 kDa protein; Interferon-induced 17 kDa protein; IP17; Ubiquitin cross-reactive protein; Ubiquitin-like protein ISG15
基因别名: G1P2; ISG15; UCRP
Entrez Gene ID: (Human) 9636



